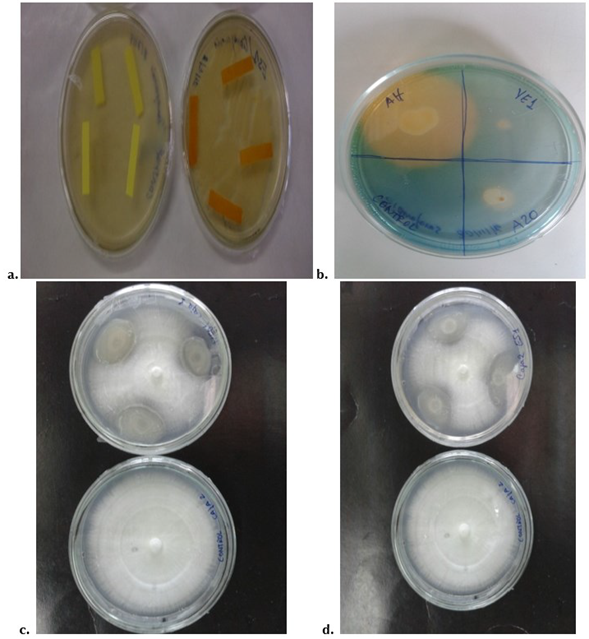

INTRODUCCIÓN
Los microorganismos antagonistas (bacterias y hongos) tienen la capacidad de ejercer un efecto de control biológico sobre diferentes fitopatógenos de interés y se han empleado para controlar diversas enfermedades en cultivos hortícolas. En cultivos comerciales las medidas de control se basan en el uso de agroquímicos, práctica que está variando a la implementación de controles biológicos con el propósito de proteger y mitigar el impacto sobre el medio ambiente (Agrios, 2005; Boukaya et al., 2018; Alcedo y Reyes, 2018; Márquez et al., 2020). Para implementar estas alternativas es necesario conocer la biología de los organismos que interactúan en los cultivos (Agrios, 2005).
Las rizobacterias forman parte de la gran cantidad de microorganismos biológicos asociados a la rizósfera que actúan como agentes de control de enfermedades fúngicas y bacterianas, tanto en la parte aérea como en la raíz de las plantas hospedadoras, además son promotoras del crecimiento y desarrollo de los vegetales (Mondino y Vero, 2006; Alcedo y Reyes, 2018). Las bacterias promotoras del crecimiento vegetal (BPCV) pueden actuar sobre la planta de dos maneras: directa, facilitando a la planta compuestos sintetizados por ellas mismas o por medio de procesos bioquímicos (fitohormonas, fijación biológica de nitrógeno, quelación de hierro y disolución de fósforo), produciendo así un beneficio a la planta; indirecta, a través del mecanismo Biocontrol-BPCV.
Varios estudios han demostrado que determinadas cepas bacterianas bajo condiciones controladas, suprimen el crecimiento de hongos fitopatógenos (Xue et al., 2015). Entre estas, las rizobacterias logran la protección de las plantas contra microorganismos fitopatógenos por medio de la competencia por espacio o nutrientes, producción de metabolitos y antibióticos, secreción de diversas enzimas hidrolíticas que degradan la pared celular de los patógenos, producción de sideróforos e incremento de la capacidad de respuesta sistémica de la planta frente a los microorganismos agresores (Bhattacharyya y Jha, 2012; Márquez et al., 2020). Dentro de este grupo se puede mencionar a las Pseudomonas (aeruginosa, fluorescens, putida), Bacillus y Burkhol-deria, que son las más usadas para el control de enfermedades en plantas (Ezziyyani et al., 2004a).
Uno de los elementos esenciales para el crecimiento y desarrollo de la mayoría de los microorganismos que habitan en el suelo es el hierro, debido a su función en reacciones enzimáticas de óxido-reducción (Hernández et al., 2004). Algunas rizobacterias aplican cierta estrategia para asimilar este elemento cuando se encuentra en el suelo en pequeñas cantidades, produciendo una sustancia de bajo peso molecular afín al ion Fe+, denominado sideróforo, que se encarga de atraparlo impidiendo que esté disponible para otros microorganismos, ejerciendo así el control biológico de enfermedades importantes, tales como Fusarium sp., Pythium sp., Rhizoctonia sp. y Phytophtora sp. (Bagg y Neilands, 1987; Kundan et al., 2015).
Otro de los compuestos producidos por estos microorganismos es el ácido cianhídrico (HCN), que tiene funciones como elicitor de la respuesta sistémica inducida, así como promotor del crecimiento y de antagonista contra hongos fitopatógenos (Meldau et al., 2013). Sin embargo, estas sustancias, producidas en grandes cantidades, pueden alterar considerablemente la actividad fisiológica de la planta (Compant et al., 2005). También se ha observado que el HCN actúa como un agente eficaz para el biocontrol de las malas hierbas, y que inhibe la acción de la citocromo oxidasa (Kundan et al., 2015).
Algunos de los hongos fitopatógenos más comunes del suelo que afectan los cultivos hortícolas, son Fusarium oxysporum (Schltdl.), y Rhizoctonia solani (J. G. Kühn). Existen otros patógenos comunes que inciden sobre el follaje como Colletotrichum gloeosporioides (Penz.) Penz. y Sacc. El control de estos fitopatógenos se hace con la aplicación de fungicidas de amplio espectro; sin embargo, estas estrategias de control químico han generado la emergencia de cepas resistentes, además de efectos negativos en la salud pública y el medio ambiente (Fravel et al., 2003). Sus efectos negativos constituyen una limitante para la producción, ocasionando pérdidas económicas en las zonas agrícolas del estado Mérida, Venezuela. Esta problemática permite plantear el uso de estrategias de control biológico, importantes para la recuperación del equilibrio de los agroecosistemas y para el aprovechamiento del potencial antagonista natural de ciertos microorganismos autóctonos como hongos y rizobacterias contra patógenos vulnerables (Avendaño et al., 2006; Márquez et al., 2020).
Con base en lo anterior, el objetivo de esta investigación fue evaluar in vitro la actividad microbiana de las rizo-bacterias como potenciales antagonistas de los hongos F. oxysporum, C. gloeosporioides y R. solani y algunos mecanismos directos e indirectos que pueden estimular el crecimiento vegetal para promover su utilización en la agricultura sostenible.
MATERIALES Y MÉTODOS
Material biológico
Se utilizaron diez cepas rizobacterianas aisladas de diferentes zonas del estado Mérida, Venezuela y preservadas en el Laboratorio de Fitobiotecnología-ULA, que mostraron potencial biofertilizante sobre pimentón y lechuga (Blanco et al., 2018). Las cepas usadas fueron ME01 (Rhizobium tropici), Nod2rojo (Bradyrhizobium japonicum) y RmBorbollón (Sinorhizobium spp.) (Marquina et al., 2011), Leu2A (Bradyrhizobium japonicum), CP, YE1 y Med (Bradyrhizobium spp.), ES1 y EV1 (Ochrobactrum spp.) y Alf (Pseudomonas fluorescens) (Blanco et al., 2018). Los fitopatógenos utilizados fueron tres cepas almacenadas en el Laboratorio de Fitopatología IIAP-ULA e identificados como Fusarium oxysporum, Colletotrichum gloeosporioides y Rhizoctonia solani.
Pruebas fisiológicas
Se probó la tolerancia a la salinidad de las rizobacterias en medio agarizado extracto de levadura-manitol YMA modificado con 0.5 g.L-1 K2HPO4, 0.2 g.L-1 MgSO4.7H2O, 0.1 g.L-1 NaCl, 0.5 g.L-1 extracto de levadura, 2.5 g.L-1 manitol, 7.5 g.L-1 sacarosa, 2.5 mg.mL-1 rojo congo pH 6.7 -6.8 (Vincent, 1975) a 29 °C, desde 0.01 % hasta 2.5 % de NaCl. En el mismo medio se probó el crecimiento en temperaturas desde 5 °C hasta 40 °C. Adicionalmente se verificó la producción de ácido o álcali en medio ELMABAT durante tres días a 29 °C (Ferrera et al., 1993).
Pruebas bioquímicas
Se determinó la producción de ácido cianhídrico (HCN) por el método cualitativo modificado por Wei et al. (1991), mediante siembra por agotamiento de las rizobacterias en placas con medio TSA suplementado con 4.4 g.L-1 de glicina, en las que se colocaron en la tapa de la placa de Petri tiras de papel filtro sumergidas en una solución de carbonato de sodio 12,5 % y ácido pícrico 2.5 %, indicando producción de HCN mediante un cambio de coloración de las tiras de amarillo a anaranjado-marrón (moderado) y amarillo a rojo (fuerte) durante 2-4 días (Bakker y Schippers, 1987; Wei et al., 1991).
La producción de sideróforos se detectó por la prueba del Cromo Azurol-S (CAS) (Schwyn y Neilands, 1987), en sustrato base medio B de King (Glickmann y Des-saux, 1995). La producción positiva de sideróforos se observó mediante la formación de un halo anaranjado-amarillo alrededor de la colonia de cada rizobacteria.
La fijación de N se determinó mediante el crecimiento en medio manitol (Holt y Krieg, 1994). La actividad disolvente de fosfatos se determinó incubando 10 μL de cada inóculo rizobacteriano 1 x 108 cel.mL-1 de medio salino 0.80 % NaCl, en medio mínimo (MM) sólido suplementado con fosfato tricálcico, y observando el halo de disolución (Reyes et al., 1999). La temperatura de incubación para todas las pruebas fue 29 °C.
Medición cuantitativa de AIA
La producción de ácido indol-acético (AIA) se determinó con base a los protocolos de Bric et al. (1991) y Glickmann y Desaux (1995). Las concentraciones de AIA empleadas para la curva patrón fueron 0, 5, 10, 15, 20, 25, 30, 35, 40, 45, 50 μg.mL-1. Se evaluó la producción de AIA en ausencia y presencia de 0.5 mg.mL-1 de L-triptófano (Glickmann y Dessaux, 1995). Para esto se incubaron 500 μL de inóculo 1x108 cel.mL-1 de las rizobacterias en 3 mL de MM (Reyes et al., 1999) suplementado o no con 0,5 mg.mL-1 de triptófano (Trp) durante 120 h en oscuridad y agitación de 120 rpm a 30 °C. Posteriormente para cada tratamiento se tomaron 2,5 mL del cultivo en un tubo eppendorf y se centrifugaron por 10 minutos a 4 000 rpm. El reactivo de Salkowski se preparó con la relación 2:1 de FeCl3 10 mM y HClO4 3.5 M respectivamente (Bric et al., 1991), y para la reacción se preparó una proporción 1:2 con el AIA (sobrenadante) y el reactivo de Salkowski, respectivamente. Las muestras reaccionaron durante 30 minutos en oscuridad y se determinó la concentración de AIA a 530 nm en un espectrofotómetro de luz visible (Spectronic 20). Se utilizaron tres réplicas por tratamiento, y se usó como blanco el MM estéril suplementado con Trp. También se incluyó Azospirillum brasilense (Sp7) como control microbiano positivo (Dobbelaere et al., 1999), y un control de MM estéril en solución salina a 0.89 % NaCl.
Ensayo de actividad antagónica
Se evaluó el potencial biocontrolador in vitro de las rizo-bacterias sobre F. oxysporum, C. gloeosporioides y R. solani mediante enfrentamientos en placas de Petri (Ezziyyani et al., 2004b) conteniendo medio PDA (Cañedo y Ames, 2004). Se colocó por triplicado 10 |L del inóculo 1 x 108 cel.mL-1 cada rizobacteria a 3 cm de distancia entre sí, y a las 24 h de incubación a 29 °C, se colocaron discos de agar de 8 mm de diámetro de cada fitopatógeno en estado de micelio (5-8 días de crecimiento) y se incubó a temperatura ambiente (22 °C aproximadamente) durante 8 días. Finalmente se midió el porcentaje de inhibición de crecimiento radial (PICR) del fitopatógeno, mediante la fórmula PICR= (R1 - R2)/ R1 x 100 (Ezziyyani et al., 2004b).
Análisis estadístico
Los resultados se analizaron mediante un ANOVA con el programa estadístico Statgraphics® en su versión 5.1. Además, se realizó la comparación de medias entre los tratamientos por el test de la mínima diferencia significativa (LSD) a P < 0.05. Las pruebas que no cumplieron con los supuestos de normalidad y homogeneidad de las varianzas (Montgomery, 1991) se sometieron a la prueba Kruskall Wallis con el programa estadístico Infostat®.
RESULTADOS
Tolerancia a la salinidad, temperatura y producción de ácido-álcali
Las rizobacterias mostraron diferentes gamas de tolerancia a la concentración de NaCl. Las cepas ME01, RmBorbollón y Med mostraron ser tolerantes a todas las concentraciones probadas, mientras que Nod2rojo y ES1 resultaron poco tolerantes a la salinidad. El resto de los aislados creció entre 0.01 y 1 % de NaCl. En cuanto a la temperatura, todas las cepas crecieron entre 11°C y 35°C. Particularmente las cepas ME01 y RmBorbollón crecieron a 40 °C, mientras que la Alf creció abundante a 5 °C. Siete cepas produjeron ácido y tres cepas produjeron álcali (Tabla 1). En general, las cepas con amplia tolerancia a la salinidad también mostraron amplia tolerancia a la temperatura.
Tabla 1 Caracterización fisiológica de las rizobacterias de acuerdo a la tolerancia a la salinidad, temperatura, y producción de ácido o álcali.

Media de tres réplicas: + Abundante crecimiento +- Escaso crecimiento - Ausencia de crecimiento
Producción de HCN, sideróforos y disolución de fosfatos De las diez cepas solo la ES1 produjo HCN, representando el 10 % de la muestra. El 50 % de las cepas ensayadas mostraron liberación de sideróforos, destancando entre ellas la cepa Alf (Tabla 2 y las figuras suplementarias Figura 1a y Figura 1b). Por otra parte, el 100 % de las cepas creció en medio manitol indicando que todas son fijadoras de nitrógeno mientras que seis cepas (60 %) mostraron capacidad disolvente de fosfatos en el medio MM con fosfato tricálcico como fuente de P (Tabla 2).
Tabla 2 Caracterización bioquímica de las rizobacterias según la producción de HCN, sideróforos, fijación de nitrógeno y disolución de fosfatos.

Media de tres réplicas. +: indica crecimiento o producción según el caso ++: indica alta producción -: indica ausencia de creci miento o producción según el caso.
Producción de AIA
Cinco cepas utilizadas produjeron AIA de forma significativa (P < 0.05) con respecto al control (sin bacteria) en presencia de Trp, y con valores cercanos al control positivo Sp7. Los valores de AIA obtenidos por las cepas rizobacterianas estuvieron entre 1 8,07 ug-mL-1 para la cepa Leu2A y 52,28 ug-mL-1 para la cepa YE1, esta última mostró una producción altamente significativa (Figura 2)- Ninguna cepa fue capaz de producir AIA en ausencia de Trp.
Figura 1 Pruebas de HCN, sideróforos y antagonismo a. Viraje de color de la tira de papel filtro por la producción de HCN por ES1 a las 48 h de crecimiento b. Producción de sideróforos por las cepas Alf y YE1. c. ME01 Vs F. oxysporum a los 8 días de crecimiento d. ES1 Vs. F. oxysporum a los 8 días de crecimiento.

Figura 2 Producción de AIA por las rizobacterias en presencia y ausencia de triptófano. * Indica diferencias significativas (P < 0.05) con respecto al tratamiento control con la prueba de Kruskal Wallis. N=3. Sp7= cepa control productora de AIA Azospirillum brasilensi; Control= Solución NaCI 0.89 %; Tratamientos" Solución NaCI 0.89 % + cepa; Trp= triptófano.
Tabla 3 Evaluación del crecimiento (cm) del fitopatógeno frente al biocontrolador y porcentaje de inhibición de crecimien to radial (PICR) de los hongos ensayados frente a los distintas cepas de rizobacterias, a los siete días de enfrentamiento.

Medias de tres réplicas. Letras diferentes indican diferencias significativas para ANOVA con un (P< 0.005). Control = Fitopatógeno sin microorganismo biocontrolador. N=3
Antagonismo de rizobacterias contra fitopatógenos:
Las cepas ensayadas inhibieron significativamente el crecimiento de F. oxysporum y C. gloeosporioides (P < 005)- Nueve de las diez cepas resultaron antagonistas de F. oxysporum inhibiendo por encima del 40 % el crecimiento del hongo. La cepa ME01 mostró el mayor potencial como biocontrolador tras inhibir el crecimiento del fitopatógeno F. oxysporum en 65 % (Tabla 3 y las figuras suplementarias Figura 1c y Figura 1d), y tender a inhibir a C. gloeosporioides en 11 %. Por su parte, la cepa Alf fue la única que inhibió significativamente (P < 0.05) el crecimiento de C. gloeosporioides en 22 %. Ninguna cepa inhibió el crecimiento de R. solani (Tabla 3).
DISCUSIÓN
En este estudio se demuestra el gran potencial que tienen las rizobacterias, especialmente los rizobios como posibles biofertilizantes y biocontroladores, además de su uso bien conocido en simbiosis con plantas leguminosas para la fijación biológica del N, pues las pruebas aquí utilizadas representan la mayoría de los mecanismos promotores del crecimiento vegetal que presentan los microorganismos del suelo (Vessey, 2003; Antoun, 2012). La caracterización fisiológica de las rizobacterias permite discernir entre las que crecen en amplio rango de condiciones ambientales y las que no, para seleccionarlas como posibles inoculantes y ser probadas en campo de acuerdo a las características que presenten.
La capacidad disolvente de fosfatos reside en la producción de ácidos orgánicos que hacen disponible el P para las plantas (Paredes-Mendoza y Espinosa-Victoria, 2010). Principalmente estos ácidos orgánicos han sido descritos como ácido glucónico y ácido cítrico para el caso de bacterias y hongos, mientras que para las bacterias, también se ha mencionado el mecanismo de extrusión de protones (Reyes et al., 1999). Estos mecanismos explican la disolución de fosfatos de calcio mostrada por seis cepas en nuestro ensayo.
El proceso de oxidación de la glucosa a ácido glucónico podría considerarse como una estrategia competitiva para transformar las fuentes de carbono disponibles en productos que pueden utilizar con menos facilidad otros microorganismos (Goldstein, 1995). La fijación biológica de nitrógeno es fundamental dentro del grupo de rizobios, y convierte a estos simbiontes facultativos en un grupo exitoso del suelo, gracias a que pueden tener un metabolismo versátil (heterotrofía variable, respiración aeróbica, microaeróbica y anaeróbica), que permite usar estos microorganismos como promotores del crecimiento vegetal no solo en legumbres sino en cereales y otros cultivos (Iyer y Rajkumar, 2018).
La prueba fisiológica de producción de HCN, difirió de la obtenida en otras investigaciones en donde entre el 22 % y el 33 % de la población microbiana analizada, perteneciente a géneros bacterianos no rizobiales, fue capaz de producir este compuesto volátil (Dinesh et al., 2015; Aliyat et al., 2020). La producción de metabolitos de bajo peso molecular como el HCN inhibe el transporte de electrones y, por lo tanto, la interrupción del suministro de energía a las células (Gopalakrishnan et al., 2015). De esta manera, la cepa ES1 no solo podría ejercer un efecto biocontrolador sobre fitopatógenos, sino también sobre pastos que se consideren malezas, tal como el metabolito producido por Pseudomonas sp. como lo indicaron Pacheco-Hernández et al. (2015).
Asimismo, la cepa ES1 del orden rizobial fue capaz de cometabolizar fungicidas carbamatos en presencia de una fuente de carbono (Blanco et al., 2013), pudiendo utilizarse esta cepa como biofertilizante, biorremediador y biocontrolador potencial, por su capacidad de disolución de fosfatos naturalmente bajo condiciones de estrés, como lo reportaron Anzuay et al. (2017), quienes demostraron que algunas cepas rizobacterianas de Serratia sp., Pantoea sp., Acinetobacter sp., Bacillus sp., Enterococcus sp., y P. fluorescens son capaces de disolver fosfatos en presencia de pesticidas, y su tolerancia a altas temperaturas y altas concentraciones de NaCl, como fue evaluado en la presente investigación.
Los valores de AIA mayores a 18 ug.mL"1, fueron similares a los producidos en aislados provenientes de nódulos de leguminosas y suelo rizosférico por Mota et al. (2014) y en cepas no rizobiales por Boukaya et al. (2018) y Márquez et al. (2020). Estos valores indican que las cepas rizobiales Leu2A, ME01, CP, ES1 y YE1 tienen potencial para ser usadas como bioestimulantes del crecimiento vegetal en campos cultivados, y que a nivel de umbráculo también pueden ser efectivas como lo demostraron Blanco et al. (2018) con plántulas de pimentón y lechuga usando estas cepas de rizobios de forma individual, y Castro y Blanco (2018) y Blanco et al. (2021) aplicando consorcios de estas cepas en plantas de pimentón y en plántulas de cebolla, respectivamente. El ácido indol acético es la fitohormona que acelera el crecimiento vegetal y mejora el desarrollo de la raíz, brotes y el vigor de las plántulas; está involucrado en la división celular, la diferenciación de los haces vasculares y es esencial en la formación del nódulo (Gopalakrishnan et al., 2015).
La capacidad antagónica de algunos géneros microbianos radica principalmente en la producción de moléculas tóxicas, la competencia por nutrientes y espacio, y la alteración de la fisiología de la planta hospedadora en beneficio de su población, lo que permite mantener el equilibrio poblacional (Palaniyandi et al., 2011). Los sideróforos producidos por las BPCV pueden ejercer un efecto biocontrolador además de biofertilizante, debido a que privan del hierro a fitopatógenos y limitan el crecimiento de estos, constituyendo así un mecanismo de competencia por el ión férrico. En la presente investigación varios géneros de rizobios resultaron positivos para la producción de sideróforos, y en la cepa Alf (Pseudomonas fluorescens) se observó la mayor producción de estos quelantes, así como en el estudio de Aliyat et al. (2020), en donde cepas del género Pseudomonas mostraron muy alta producción de sideróforos.
Los rizobios son también conocidos como agentes importantes de biocontrol de patógenos en ecosistemas naturales y agrícolas (Mourad et al., 2009; Volpiano et al., 2019). En el presente estudio, se encontró que las cepas rizobiales ME01 (Rhizobium tropici), RmBorbollón (Sinorhizobium spp.), Leu2A y Nod2rojo (Bradyrhizobium japonicum) inhibieron el crecimiento de F. oxysporum por encima de un 50 %, al igual que los resultados obtenidos por Antoun et al. (1998) donde 49 cepas de Sinorhizobium meliloti inhibieron el crecimiento de F. oxysporum hasta en un 50 %. A su vez la cepa Alf (Pseudomonas fluorescens) inhibió el crecimiento tanto de F. oxysporum como de C. gloeosporioides, mostrando así un rango de biocontrol más amplio.
La eficiencia antagónica de estos y otros géneros rizobac-terianos contra hongos fitopatógenos es generalmente mediada por uno o más mecanismos, como la producción de sustancias antimicrobianas, competición por nutrientes debido a la producción de sideróforos, bloqueo de sitios de entrada o activación de mecanismos de defensa del hospedador, y producción de enzimas quitinolíticas, sustancias volátiles, y endoglucanasas (Aysan y Demir, 2009; Márquez et al., 2020; Galeano et al., 2020), por lo que este efecto puede deberse a un pool de mecanismos implicados en el biocontrol de fitopatógenos.
CONCLUSIONES
La mayoría de las rizobacterias evaluadas mostraron un efecto antagónico contra dos de los fitopatógenos evaluados de importancia agrícola por encima del 50 % de inhibición. La naturaleza biocontroladora de estas bacterias además se comprobó mediante otros mecanismos evaluados como la producción de sideróforos y HCN. Las rizobacterias también mostraron potencial como promotoras del crecimiento vegetal a través de los mecanismos de fijación de nitrógeno, disolución de fosfato, y producción de AIA. De esta forma se destacó el potencial que tienen las cepas rizobiales ES1, ME01, Leu2A, y YE1, y la cepa Alf de Pseudomonas flurorescens para incrementar la fertilidad del suelo, promover el crecimiento de las plantas, y suprimir enfermedades con fines de producción de bioinsumos en la agricultura sostenible. Se recomienda evaluar consorcios de estas cepas para potenciar sus efectos benéficos en cultivos de interés agrícola.














